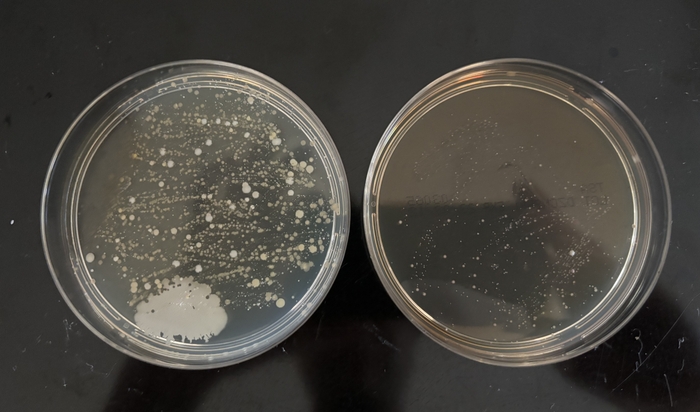
抗菌試験(左)抗菌材無し(右)廃木材から合成した量子ドット抗菌材あり

廃木材、廃紙、オレンジの皮などのバイオマス資源廃棄物から GSアライアンスが量子ドット型抗菌剤を開発
脱炭素、カーボンニュートラル社会構築のための最先端技術を研究開発するGSアライアンス株式会社の森良平博士(工学)は、廃木材、廃紙、オレンジの皮などのバイオマス資源廃棄物から、量子ドット型抗菌剤を開発しました。
抗菌薬は細菌感染症の治療で使用される薬です。菌に影響を与える物質としては、抗生物質、プロバイオティクス、バクテリオファージ、抗菌ペプチド、ナノ材料などがあります。化学合成、微生物からの合成、天然物から合成される抗生物質と比較して、ナノ材料、ナノ微粒子は、細菌との相互作用が、これらの従来の抗生物質より、より強くなる可能性があります。ナノ微粒子は、その数ナノメートルという超微小サイズ、及び表面の官能基の存在などの理由で菌の細胞壁、細胞膜により強く相互作用、浸透しやすいからです。このような観点から、銅や銀などのナノ微粒子が抗菌効果を有することは知られていますが、コストの面などの課題があります。
ところで、量子ドットとは、量子化学、量子力学に従う光学特性を持つシングルナノスケール(0.5~9nm)の超微細構造の最先端材料です。量子ドット1個あたりの原子、分子数は数個~数千個といわれており、人工原子、人工分子とも言われています。物質がこのサイズになってくると、量子封じ込めと言われる物理化学的効果により、量子ドットにおいての電子エネルギー準位は連続ではなく、分離が生じ、光励起による発光波長が量子ドットのサイズに依存するような現象を示すようになります。2023年にはノーベル賞の対象ともなった最先端の材料です。
GSアライアンスでは、以前から種々のこの量子ドットや、量子ドット複合材料を合成しており、この度、同社の森良平博士(工学)は、廃木材、廃紙、オレンジの皮などの植物、バイオマス資源廃棄物から、量子ドット型抗菌剤を開発しました。上述した、銀、銅などのナノ微粒子と比較して、バイオマス資源廃棄物から作られているので、コストの面でも有利です。これらバイオマス資源廃棄物から合成された量子ドットは、炭素系量子ドット、有機系量子ドットの類となりますが、これらの量子ドットが菌の細胞壁、細胞膜に付着し、その後、菌の細胞内に入り込み、遺伝子変異や活性酸素種を生じさせ、結果として、菌を破壊する効果が抗菌性の原因となっていると言われています。他にも、菌の酵素の活性を阻害して、菌のペプチドグリカンの生成を阻害して、菌にダメージを与える、などの効果もあるようです。一方で、このような量子ドットは、原料である植物中のフラボノイド、ポリフェノール、アルカロイド、カテキン、テルペノイド、サポニンなどの性質を引き継いでいる部分もあるので、それらの抗菌性の性質を反映している可能性もあります。さらに、農業に応用した場合などは、畑などにおいて、太陽光が照射された場合は、励起電子、励起子、活性酸素種などが発生し、光触媒と類似の作用で、抗菌、抗ウィルスの効果があります。
一方で、これまでの汎用の抗生物質の長年の使用により、危険な多剤耐性菌が出現していることが、最近問題になっていますが、この類の炭素系量子ドットを抗菌剤として検討した場合は、多剤耐性菌が生まれにくい、などの研究報告もあるようです。
また、本件の量子ドット型抗菌材は、抗ウィルス性、抗カビ性も有していると推測できますが、今後確認していく予定です。新型コロナウイルス対策でも頻繁に使用されたこれまでのアルコール、次亜塩素酸ナトリウムに代わる、天然、植物由来の抗菌、抗カビ、抗ウィルス剤となる可能性もあります。
GSアライアンスとしては、今後、この量子ドット型抗菌剤を、天然系抗菌剤、抗カビ剤、抗ウィルス剤、及び農薬としての応用などを検討していきます。


会社概要
商号 : GSアライアンス株式会社(冨士色素株式会社グループ)
代表者 : 代表取締役 森 良平博士(工学)
本社所在地: 〒666-0015 兵庫県川西市小花2-22-11
事業内容 : カーボンニュートラル、脱炭素、SDGs課題に取り組む環境、
エネルギー分野の最先端技術の研究開発
(国連のスタートアップ企業支援プログラムUNOPS GIC KOBEに
2020年に採択)
URL : https://www.gsalliance.co.jp/